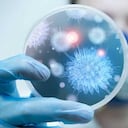
#1 Los investigadores Viktor Lemeshko y Sergio Orduz de Medellín identificaron que un tipo de péptido (grupo de aminoácidos) es capaz de combatir la bacteria responsable de la enfermedad diarreica grave (EDA), así como el origen de la foliculitis, conjuntivitis, meningitis y neumonía. De igual manera, establecieron que el péptido combate el microorganismo responsable del 10% de las infecciones nosocomiales (las que se adquieren en centros de salud).

Los bronquios son dos tubos que van desde la tráquea y llevan aire a los pulmones. Según la Biblioteca Nacional de Medicina de Estados Unidos, la afección más común de estos órganos es la bronquitis, una inflamación que puede ser aguda o crónica.

La bronquitis aguda es muy frecuente y normalmente se produce a partir de un resfrío u otra infección respiratoria; mientras que la crónica es una enfermedad más grave, pues se trata de una irritación o inflamación continua del revestimiento de los bronquios, normalmente por fumar, precisa el instituto de investigación Mayo Clinic.

La bronquitis aguda, también conocida como resfriado, suele mejorar a la semana o a los diez días sin efectos duraderos, aunque es posible que la tos permanezca durante un poco más de tiempo.
No obstante, los expertos aseguran que si una persona presenta episodios recurrentes se debe prestar atención, pues puede ser bronquitis crónica, la cual requiere atención médica. “La bronquitis crónica es uno de los trastornos de la enfermedad pulmonar obstructiva crónica”, asegura la citada fuente.
Es muy recurrente que los bronquios se congestionen y esto está relacionado con procesos infecciosos o víricos, indica una publicación de la revista Mejor con Salud. Es una situación recurrente en quienes tienen problemas de asma, alergias y en las personas que llevan muchos años fumando.

Jengibre, eucalipto y limón
Cuando se trata de afecciones agudas y no crónicas, los remedios caseros aparecen como una alternativa para mejorar la condición. Uno de ellos se prepara con jengibre, eucalipto y limón.
El jengibre posee propiedades expectorantes y antibacterianas, mientras que al eucalipto se le reconoce por ser antiinflamatorio, antimicrobiano y expectorante, por lo que también es considerado una buena opción para combatir las afecciones que se generan en los bronquios.
Para preparar la infusión se requiere de un vaso de agua, jengibre rallado, una cucharada de jugo de limón, cuatro hojas de eucalipto y una cucharada de miel.

Se pone a hervir el agua, cuando llegue a punto de ebullición se añade el jengibre, las hojas de eucalipto y la miel, se deja durante 20 minutos al fuego, luego se retira y se deja que repose por 10 minutos, se cuela y se añade el limón. Esta bebida es recomendable consumirla dos veces al día.
Otras opciones
Otra opción natural para hacerle frente a la bronquitis es tomar té de malva, ya que posee propiedades mucilaginosas que calman la irritación de la mucosa, disminuyendo la molestia causada por esta afección.

Para prepararlo se requiere de dos cucharadas de hojas secas de malva y una taza de agua hirviendo. Según información del portal de salud Tua Saúde, se adicionan las hojas de malva al agua hirviendo y se deja reposar por 10 minutos. Se cuela y se bebe tres veces al día.

Una alternativa más es el jugo de limón. Mejor con Salud indica que la evidencia respalda el uso de esta bebida y tés con sabor a esta fruta cítrica para la prevención y el tratamiento de resfriados, tos y gripa, debido a que contiene una gran cantidad de vitamina C y antioxidantes.
Se puede usar el jugo de un limón y una taza de agua. Se calienta el agua y se añade el jugo, se mezcla bien y se espera unos cinco minutos antes de beberlo. La recomendación es no consumir más de tres vasos al día.

Consejos para prevenir la bronquitis
El portal Cinfasalud, de España, realiza recomendaciones tendientes a evitar afecciones en los bronquios.
- Lavarse las manos con frecuencia. Lavarse con jabón y suficiente agua y especialmente si se ha estado en contacto con alguna persona enferma.
- No fumar y alejarse de los ambientes con humo. El tabaco inflama e irrita los conductos bronquiales, lo que puede desencadenar una bronquitis aguda, además de producir, a largo plazo, una crónica.
- Tomar precauciones en el trabajo. Si la persona debe desempeñar labores en ambientes contaminados por gases, polvos o sustancias químicas, es importante usar una mascarilla o tapabocas.

- Protegerse del frío. Evitar a toda costa los cambios bruscos de temperatura y abrigarse bien.
- Vacunarse contra la gripa. Si la persona pertenece a un grupo de riesgo como tener más de 60 años, estar embarazada o padecer alguna enfermedad pulmonar crónica, es importante vacunarse contra los virus de la gripa, que en muchos casos son responsables de la bronquitis aguda.
- Beber mucho líquido. Los líquidos, además de hidratar, ayudan a diluir los mocos y a mantener las membranas bronquiales húmedas.
